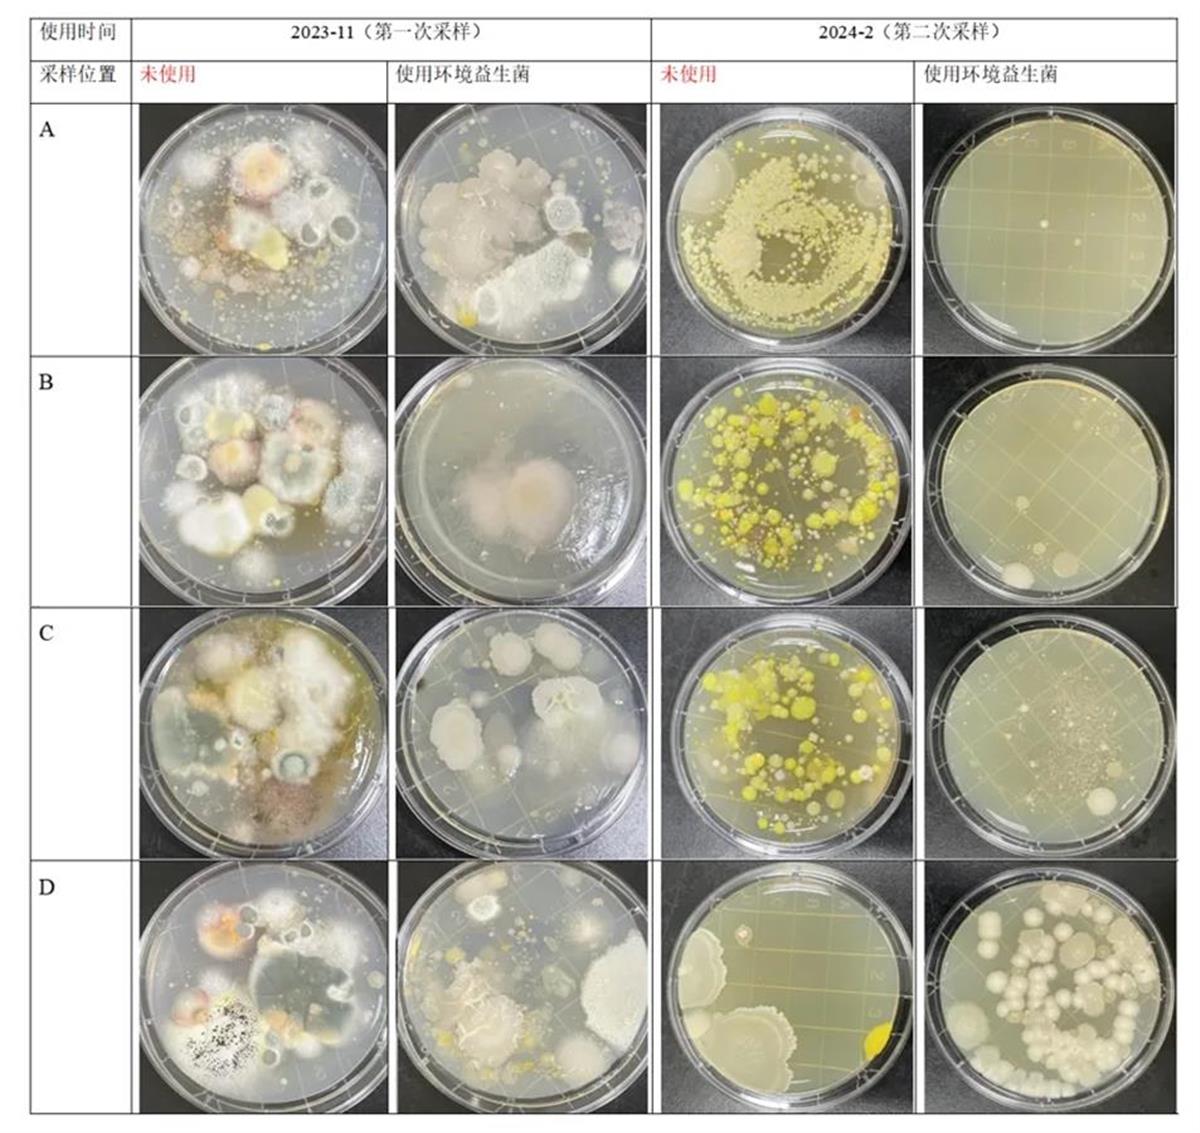
1.jpg

极目新闻记者 云迎 胡浩
6月25日,武汉悦呼吸科技有限公司发布与一家五星级酒共建的“益生菌安心房”环境评测结果,发现与未使用环境益生菌前相比,霉菌和致病菌检测均未能检出。
时下,商旅过程中,酒店已不再是出差、旅程的落脚点,更是现代人渴望放松的港湾。除了以往十分注重的客房陈设与功能,室内空间是否干净整洁,逐渐成为影响人们选择酒店的关键因素。而随着酒店星级的升高,对酒店室内空间的干净和舒适程度的要求也越来越严苛。
对此,悦呼吸与一家五星级酒共建了“益生菌安心房”,并通过采用“沙氏葡萄糖琼脂接触皿按压法”采集样本,并依据菌落形态观察法进行评估,一系列数据显示:悦呼吸环境益生菌能全面改善酒店室内环境。
悦呼吸对某五星级酒店进行了两次环境采样,第一次采样时实验房间试用产品一周,第二次采样时实验房间试用产品三个月。每个房间重点采样4个点,沙发,地毯,床,卫生间。使用悦呼吸全净化器之前:使用频率较高的房间环境中总菌落多达800CFU/100cm²,致病菌占比>10%,细菌种类多达15种,霉菌11种。
使用悦呼吸全净化器之后:(两次采样结果对比)
通过结果可知第一次采样时对照房间有大量霉菌和细菌,使用产品一周的房间里的霉菌和细菌均得到有效控制;第二次采样时对照房间有大量细菌,使用产品的房间检测到大量益生菌,无霉菌和致病菌,同时酒店反馈霉味得到有效改善。
据介绍,悦呼吸益生菌作用原理,它能够快速繁殖,迅速在环境中占据优势地位,通过竞争营养物质,有效抑制有害菌的繁殖。
这些益生菌不仅能够在数量上占据优势,更能在质量上发挥作用。它们能够吸附在病原真菌的菌丝上,生长过程中产生溶菌物质,导致菌丝断裂、解体、死亡,从根本上消除病原体的威胁。
这种“以菌治菌”的方式,不仅高效,而且环保,能真正实现对室内环境的深度净化。
此外,对于过敏体质的人群来说,环境益生菌还能有效应对过敏原的威胁,它们能够分泌蛋白酶,将多种过敏原分解为短肽,使之失去致敏性,从而避免过敏症状的发生。
无论是蟑螂、猫狗还是花粉等过敏原,都能被环境益生菌有效分解,让我们的生活空间更加健康。当益生菌覆盖在物体表面形成菌膜后,能解决污染源头,带来长效稳定的保护,这不仅是对室内环境的全面改善,更是对我们健康的深度呵护。
